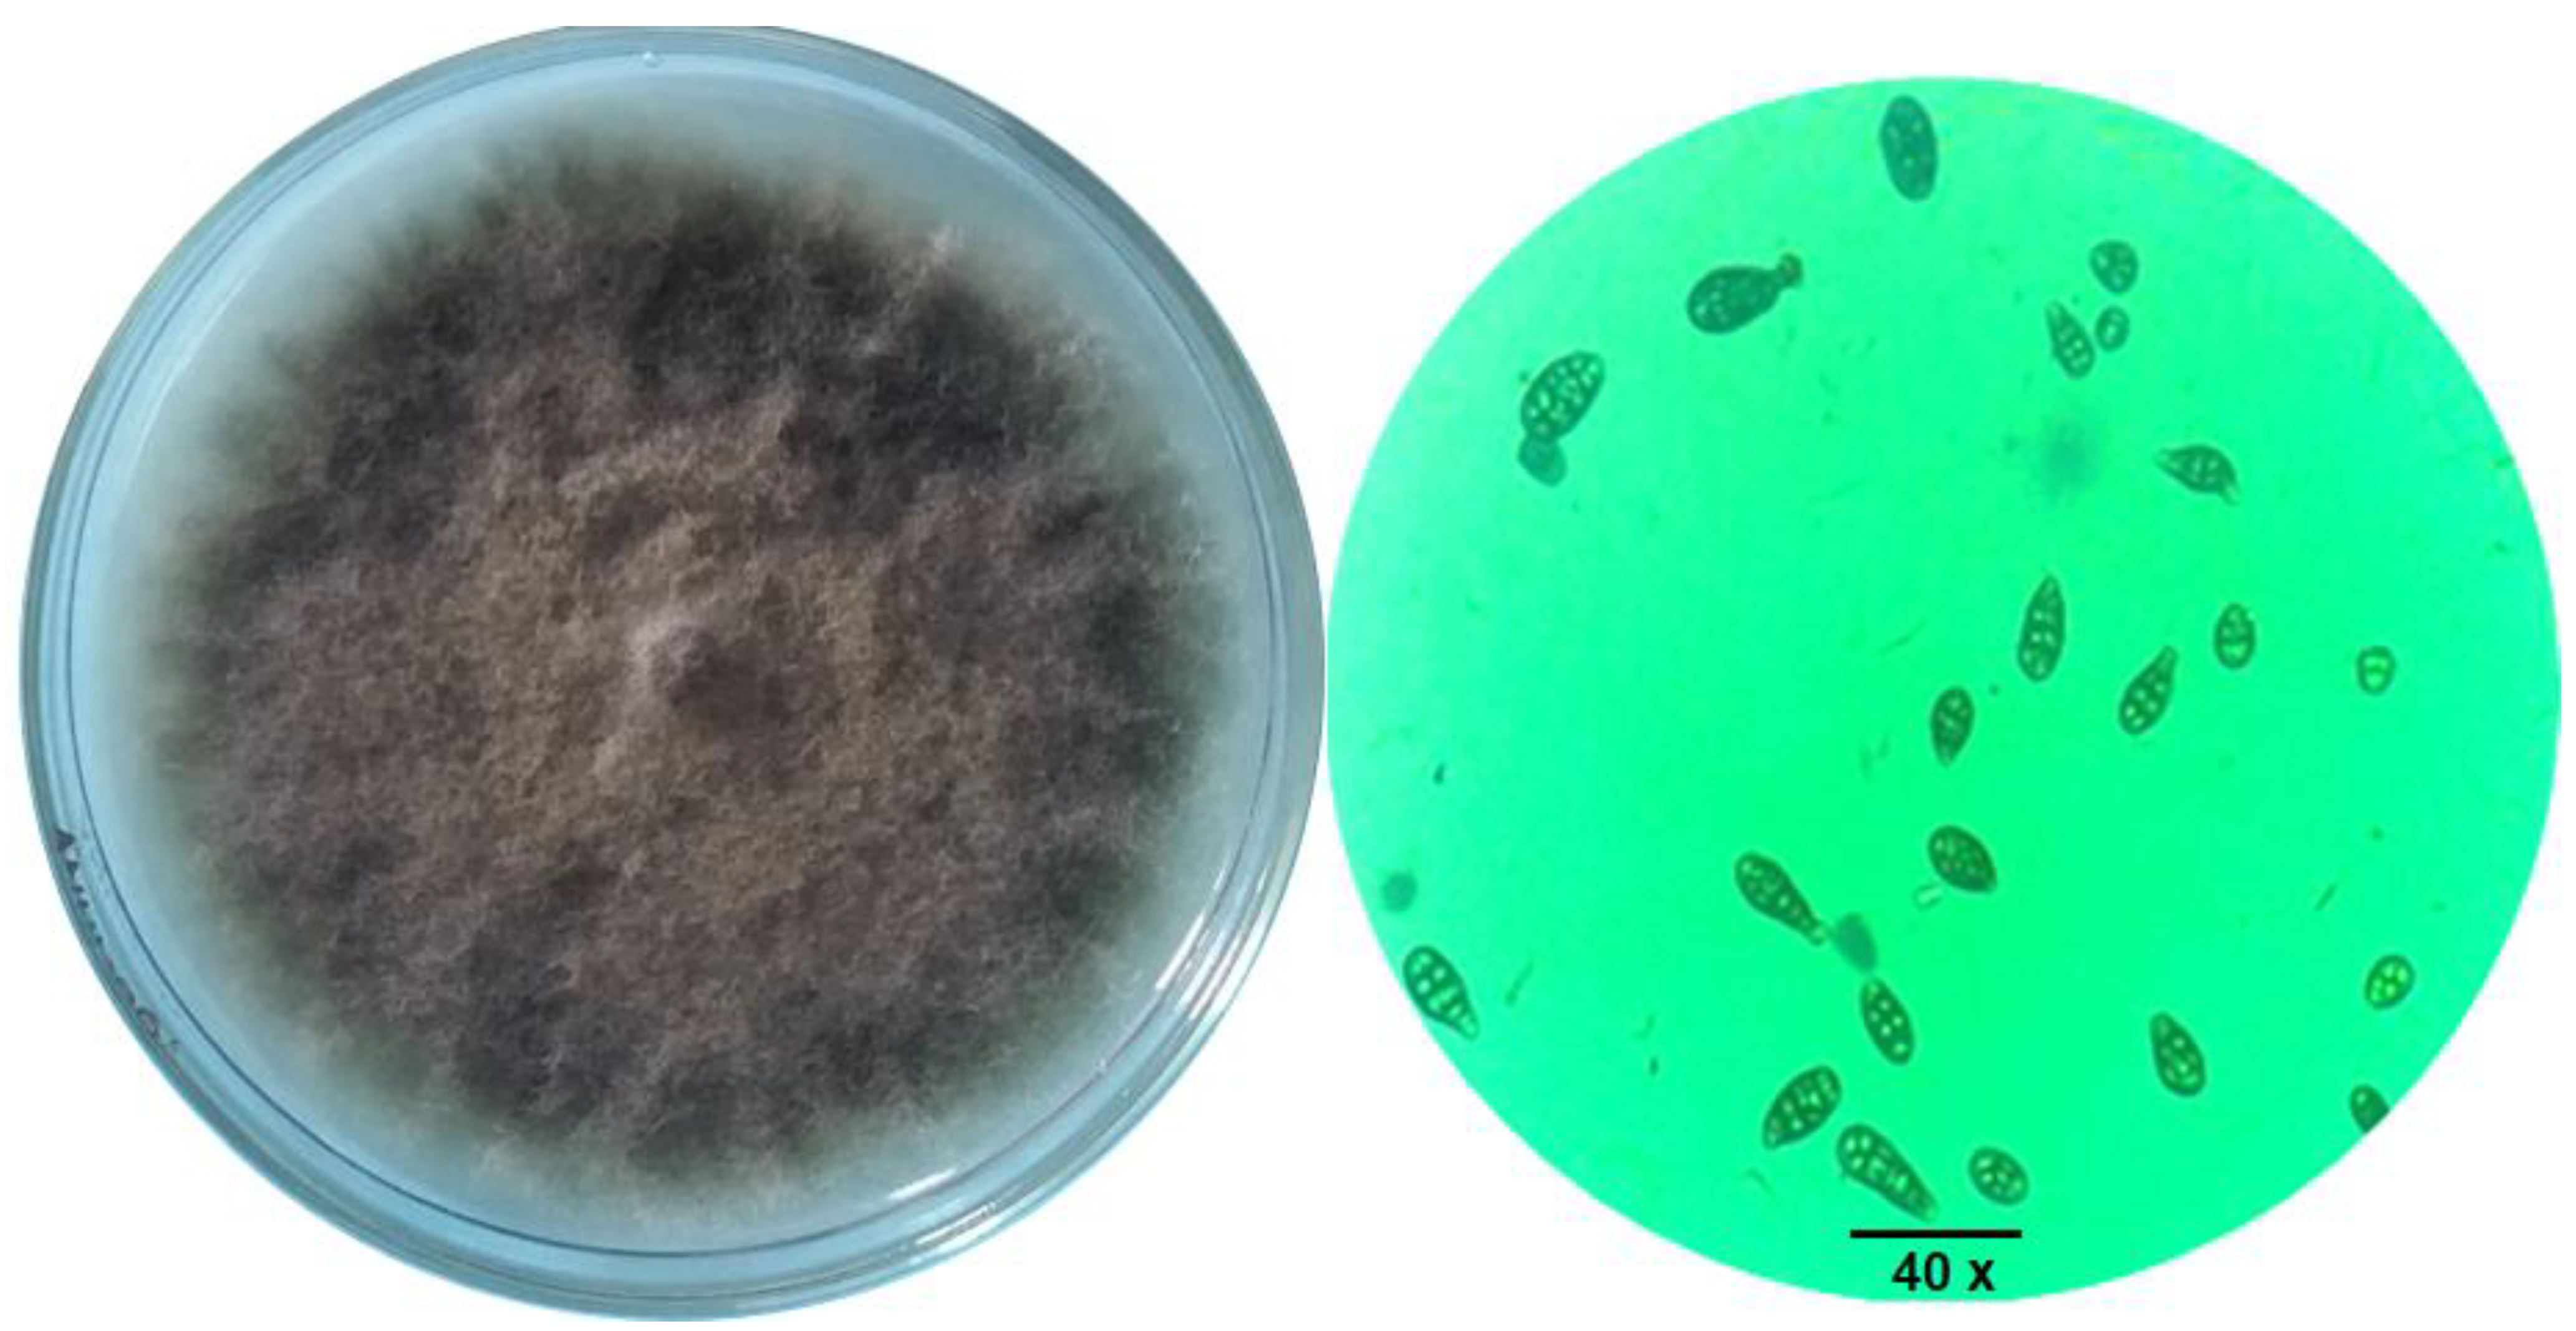
Agronomy 11 00911 g003 Agronomy 11 00911 g003
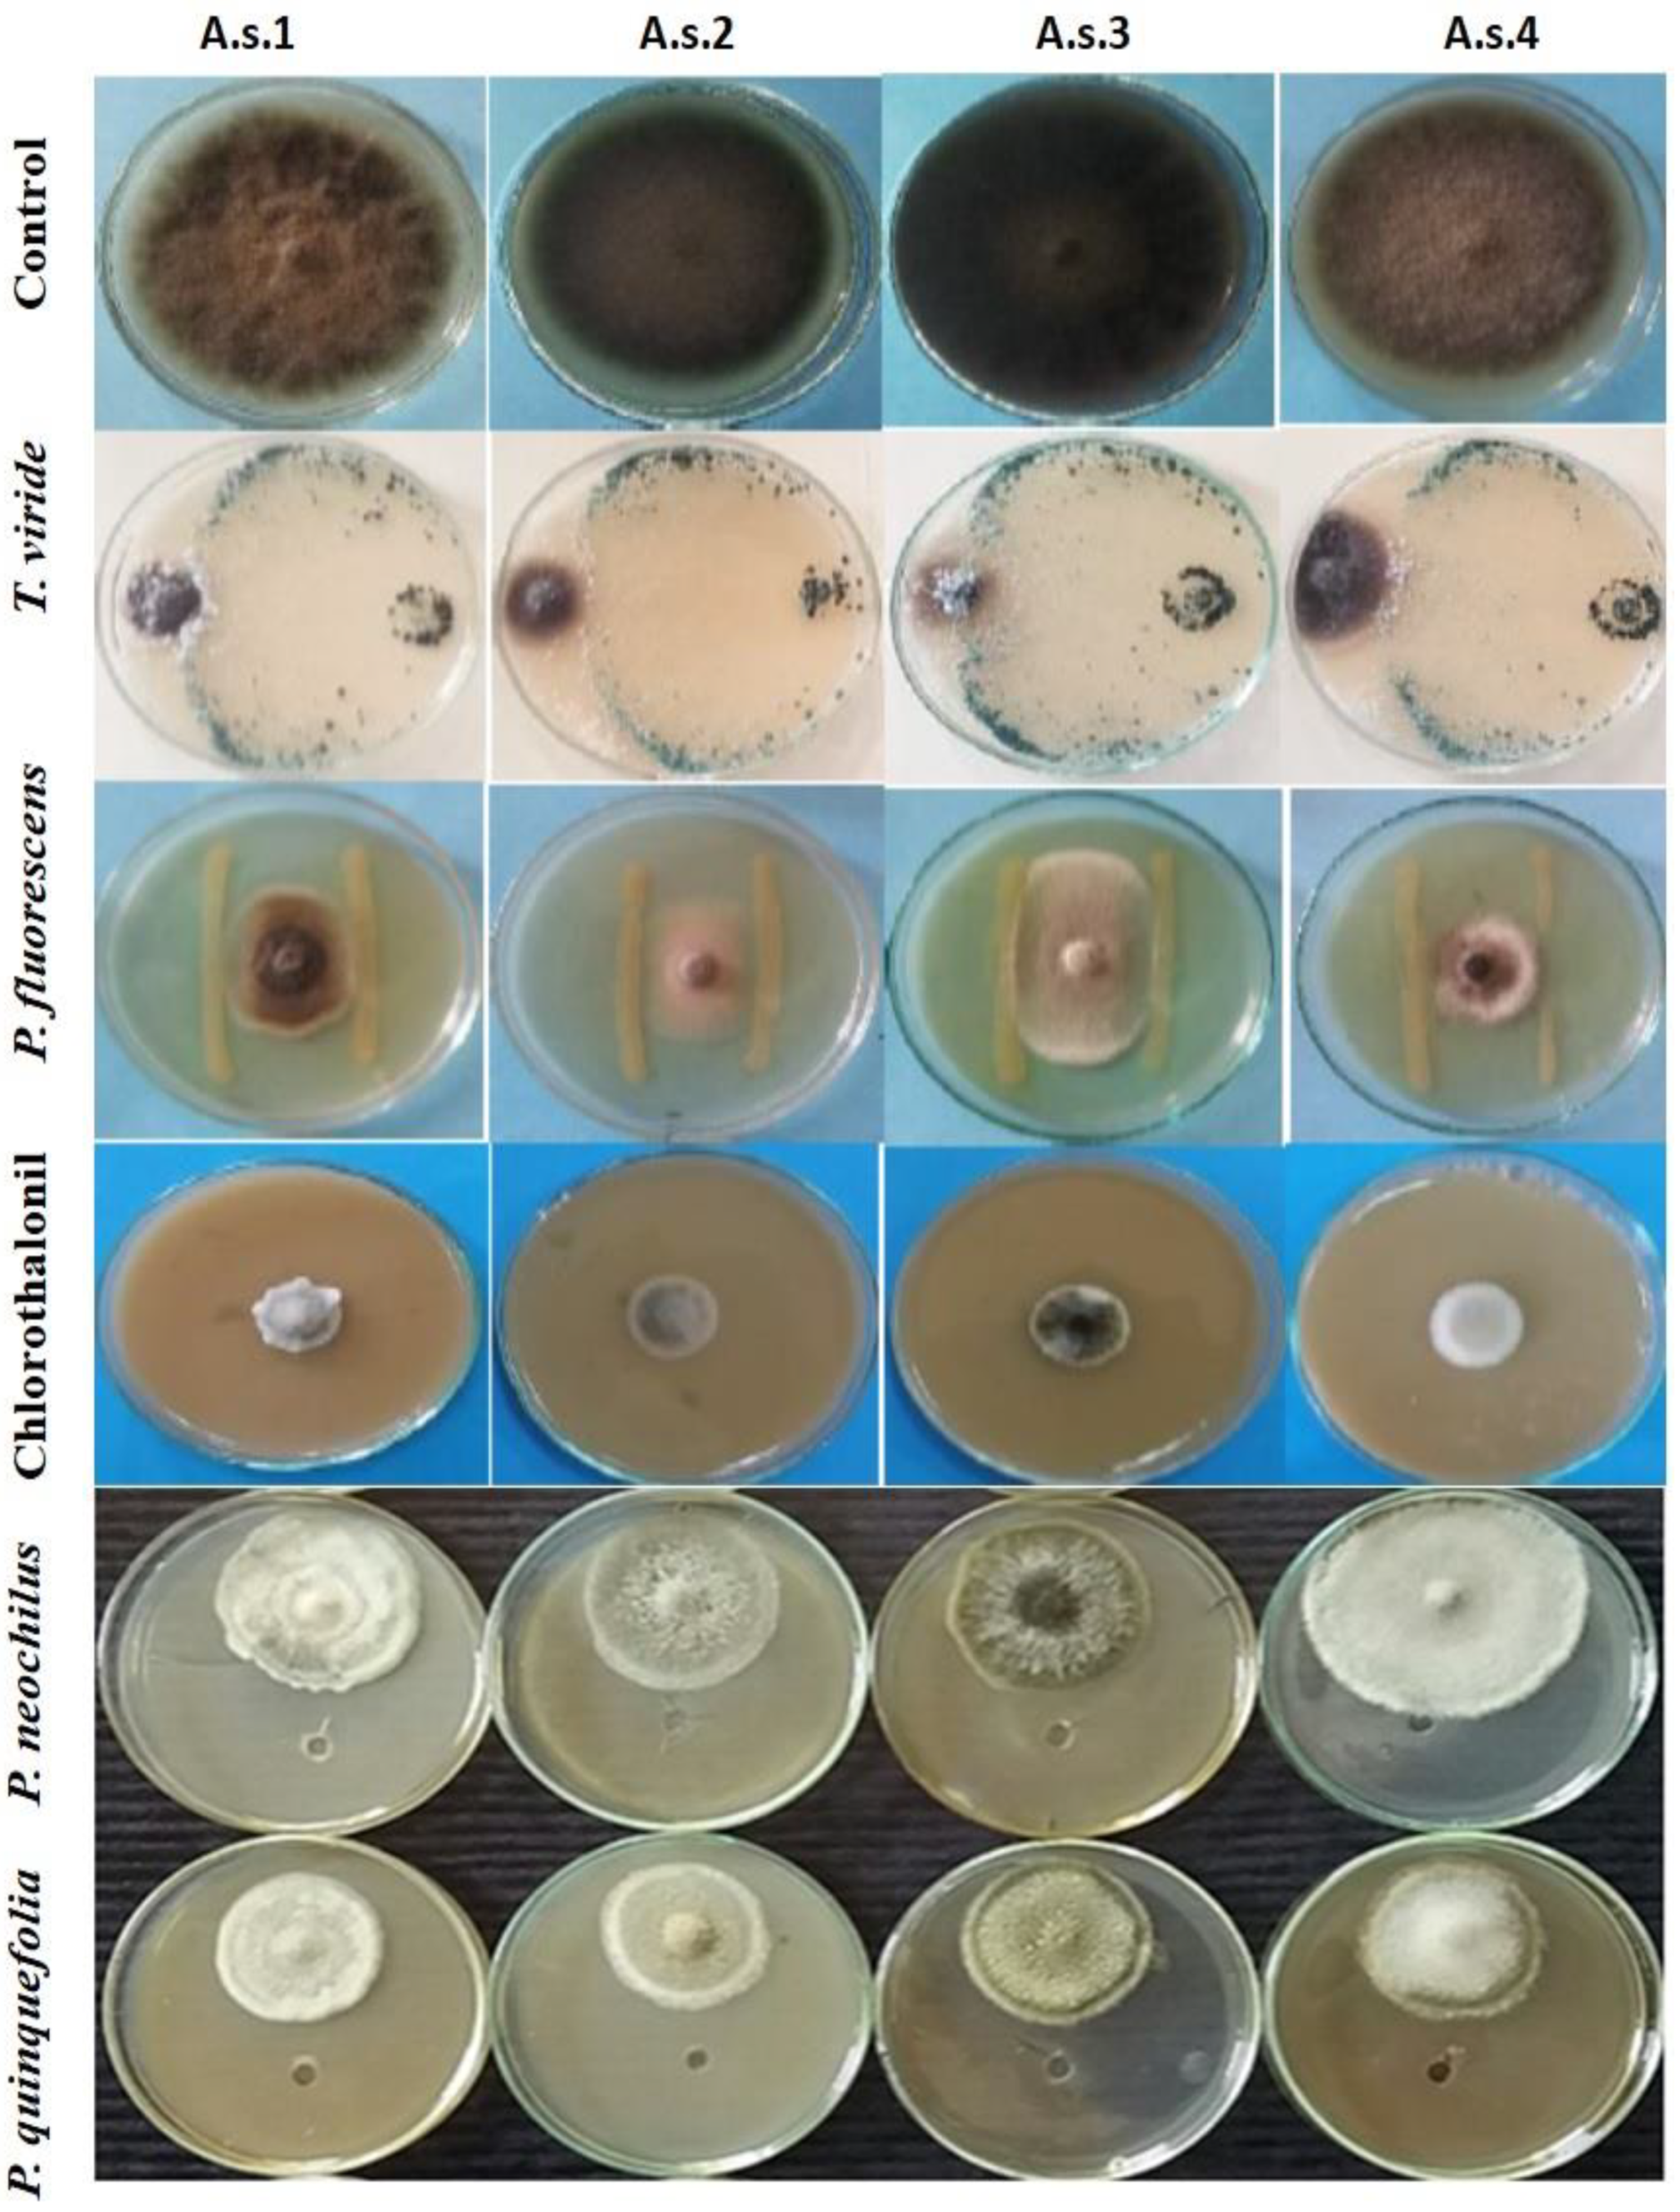
Agronomy 11 00911 g005 Agronomy 11 00911 g005

Ecofriendly Bioagents, Parthenocissus quinquefolia, and Plectranthus neochilus Extracts to Control the Early Blight Pathogen (Alternaria solani) in Tomato
Abstract
1. Introduction
2. Materials and Methods
2.1. Isolation of the Fungal Pathogen
2.2. Pathogenicity Test
2.2.1. Tomato Fruit
2.2.2. Tomato Seedlings
2.3. Identification of the Fungal Pathogen
2.3.1. Cultural and Morphological Characteristics
2.3.2. Molecular Characterization via Polymerase Chain Reaction (PCR) Amplification of the Internal Transcript Spacer (ITS) Region
2.4. Sequencing of the ITS Region and Phylogenetic Analysis
2.5. Evaluation of Bioagents and Plant Extracts against the Early Blight Pathogen Compared to a Chemical Fungicide In Vitro and In Vivo
2.5.1. Efficacy of Biological Control Agents In Vitro
2.5.2. Plant Extracts and Their Bioactivity In Vitro
2.6. HPLC Analysis of Flavonoids
2.7. In Vitro Evaluation of Fungicide
2.8. Control of Early Blight Disease in Tomato In Vivo
2.9. Statistical Analysis
3. Results
3.1. Isolation of the Fungal Pathogen
3.2. Pathogenicity Test
3.2.1. Tomato Fruits
3.2.2. Tomato Seedlings
3.3. Identification of the Fungal Pathogen
3.3.1. Cultural and Morphological Characteristics
3.3.2. Molecular Characterization through Sequence Analysis of the ITS Region and Phylogenetic Tree of Alternaria Solani Isolates
3.4. Evaluation of Bioagents, Plant Extracts and a Chemical Fungicide against A. solani Isolates In Vitro
3.5. HPLC Analysis of Flavonoids in P. neochilus and P. quinquefolia Extracts
3.6. Evaluation of Bioagents, Plant Extracts and a Chemical Fungicide against A. solani Isolates In Vivo
4. Discussion
5. Conclusions
Author Contributions
Funding
Institutional Review Board Statement
Informed Consent Statement
Data Availability Statement
Acknowledgments
Conflicts of Interest
References
- Abada, K.A.; Mostafa, S.H.; Hillal, M.R. Effect of some chemical salts on suppressing the infection by early blight disease of tomato. Egypt. J. Appl. Sci. 2008, 23, 47–58. [Google Scholar]
- Sahu, D.K.; Khare, C.P.; Singh, H.K.; Thakur, M.P. Evaluation of newer fungicide for management of early blight of tomato in Chhattisgarh. Bioscan 2013, 8, 1255–1259. [Google Scholar]
- Song, W.; Ma, X.; Tan, H.; Zhou, J. Abscisic acid enhances resistance to Alternaria solani in tomato seedlings. Plant. Physiol. Biochem. 2011, 49, 693–700. [Google Scholar] [CrossRef]
- Carneiro, S.M.; Romano, E.D.; Pignoni, E.; Teixeira, M.Z.; da Costa Vasconcelos, M.E.; Gomes, J.C. Effect of biotherapic of Alternaria solani on the early blight of tomato plant and the in vitro development of the fungus. Int. J. High. Dilution Res. 2010, 9, 147–155. [Google Scholar]
- Chaerani, R.; Groenworld, R.; Stam, P.; Voorrips, R.E. Assessment of early blight (Alternaria solani) resistance in tomato using a droplet inoculation method. J. Gen. Plant. Pathol. 2007, 73, 96–103. [Google Scholar] [CrossRef][Green Version]
- Kokaeva, L.Y.; Belosokhov, A.F.; Doeva, L.Y.; Skolotneva, E.S.; Elansky, S.N. Distribution of Alternaria species on blighted potato and tomato leaves in Russia. J. Plant. Dis. Prot. 2015, 125, 205–212. [Google Scholar] [CrossRef]
- Blancard, D.; Laterrot, H.; Marchoux, G.; Candresse, T. A Colour Handbook—Tomato Diseases: Identification, Biology and Control; Manson Publishing Manson Publishing Limited: London, UK, 2012; p. 688. [Google Scholar]
- Mallik, I.; Arabiat, S.; Pasche, J.S.; Bolton, M.D.; Patel, J.S.; Gudmestad, N.C. Molecular characterization and detection of mutations associated with resistance to succinate dehydrogenase inhibiting fungicides in Alternaria solani. Phytopathology 2014, 104, 40–49. [Google Scholar] [CrossRef]
- Khan, A.A. Resistance of two tomato species to five isolates of A. solani. Asian J. Plant. Sci. 2002, 1, 703–704. [Google Scholar] [CrossRef]
- Verma, K.P.; Singh, S.; Gandhi, S.K. Variability among Alternaria solaniisolates associated with early blight of tomato. Indian Phytopathol. 2007, 60, 180–186. [Google Scholar]
- Gannibal, P.B.; Orina, A.S.; Mironenko, N.V.; Levitin, M.M. Differentiation of the closely related species, Alternaria solani and A. tomatophila, by molecular and morphological features and aggressiveness. Eur. J. Plant. Pathol. 2014, 139, 609–623. [Google Scholar] [CrossRef]
- Bock, C.H.; Poole, G.H.; Parker, P.E.; Gottwald, T.R. Plant disease severity estimated visually, by digital photography and image analysis, and by hyperspectral imaging. Crit. Rev. Plant. Sci. 2010, 29, 59–107. [Google Scholar] [CrossRef]
- Pavóna, M.A.; Lunab, A.; de la Cruza, S.; Gonzáleza, I.; Martína, R.; Garcíaa, T. PCR based assay for the detection of Alternaria species and correlation with HPLC determination of altenuene, alternariol and alternariol monomethyl ether production in tomato products. Food Control 2012, 25, 45–52. [Google Scholar] [CrossRef]
- Rani, S.; Singh, R.; Gupta, S. Development of integrated disease management module for early blight of tomato in Jammu. J. Pharmacogn. Phytochem. 2017, 6, 268–273. [Google Scholar]
- Babu, S.; Seetharaman, K.; Nandakumar, R.; Johnson, I. Efficacy of fungal antagonists against leaf blight of tomato caused by Alternaria solani (Ell. and Mart.). J. Biol. Control 2000, 14, 79–81. [Google Scholar]
- Koley, S.; Mahapatra, S.S.; Kole, P.C. In vitro efficacy of bio-control agents and botanicals on the growth inhibition of Alternaria Solanicausing early leaf blight of tomato. Int. J. Bio-Resour. Environ. Agric. Sci. 2015, 1, 114–118. [Google Scholar]
- Sharma, R.K.; Patel, D.R.; Chaudhari, D.R.; Kumar, V.; Patel, M.M. Effect of Some Fungicides against Early Blight of Tomato (Lycopersicon esculentum Mill.) Caused by Alternaria solani (Ell. and Mart.) Jones and Grout and their Impact on Yield. Int. J. Curr. Microbiol. Appl. Sci. 2018, 7, 1395–1401. [Google Scholar] [CrossRef]
- Hernández-Ochoa, J.S.; Levin, L.N.; Hernández-Luna, C.E.; Contreras-Cordero, J.F.; Niño-Medina, G.; Chávez-Montes, A.; López-Sandin, I.; Gutiérrez-Soto, G. Antagonistic Potential of Macrolepiota sp. Against Alternaria solani as Causal Agent of Early Blight Disease in Tomato Plants. Gesunde Pflanz. 2020, 72, 69–76. [Google Scholar] [CrossRef]
- Mohamed, A.A.; Behiry, S.I.; Ali, H.M.; EL-Hefny, M.; Salem, M.Z.M.; Ashmawy, N.A. Phytochemical Compounds of Branches from P. halepensis Oily Liquid Extract and S. terebinthifolius Essential Oil and Their Potential Antifungal Activity. Processes 2020, 8, 330. [Google Scholar] [CrossRef]
- Ashmawy, N.A.; Salem, M.Z.M.; El Shanhorey, N.; Al-Huqail, A.A.; Ali, H.M.; Behiry, S.I. Eco-friendly wood-biofungicidal and antibacterial activities of various Coccoloba uvifera L. leaf extracts: HPLC analysis of phenolic and flavonoid compounds. BioResources 2020, 15, 4165–4187. [Google Scholar] [CrossRef]
- Fazli, R.; Ishtiaq, S. Integrated control of Alternaria solani with Trichoderma spp. And fungicides under in vitro conditions. Sairhad J. Agric. 2010, 26, 613–619. [Google Scholar]
- Simões, M.F.; Rijo, P.; Duarte, A.; Barbosa, D.; Matias, D.; Delgado, J.; Cirilo, N.; Rodriguez, B. Two new diterpenoids from Plectranthuss pecies. Phytochem. Lett. 2010, 3, 221–225. [Google Scholar] [CrossRef]
- Crevelin, E.J.; Caixeta, S.C.; Dias, H.J.; Groppo, M.; Cunha, W.R.; Martins, C.H.G.; Crotti, A.D.M. Antimicrobial activity of the essential oil of Plectranthus neochilus against cariogenic bacteria. Evid. Based Complement. Altern. Med. 2015, 2015, 102317. [Google Scholar] [CrossRef]
- Ticha, M.B.; Meksi, N.; Attia, H.E.; Haddar, W.; Guesmi, A.; Jannet, H.B.; Mhenni, M.F. Ultrasonic extraction of Parthenocissus quinquefolia colorants: Extract identification by HPLC-MS analysis and cleaner application on the phytodyeing of natural fibres. Dyes Pigment. 2017, 141, 103–111. [Google Scholar] [CrossRef]
- Paton, A.; Mwanyambo, M.; Culham, A. Phylogenetic study of Plectranthus, Coleus and allies (Lamiaceae): Taxonomy, distribution and medicinal use. Bot. J. Linn. Soc. 2018, 188, 355–376. [Google Scholar] [CrossRef]
- Aguiar, G.P.; Lima, K.A.; Severiano, M.E.; Groppo, M.; Ambrósio, S.R. Antifungal Activity of the essential oils of Plectranthus neochilus (Lamiaceae) and Tagetes erecta (Asteraceae) cultivated in Brazil. Int. J. Complement. Altern. Med. 2018, 11, 343. [Google Scholar]
- Caixeta, S.C.; Magalhães, L.G.; de Melo, N.I.; Wakabayashi, K.A.; de P. Aguiar, G.; de P. Aguiar, D.; Mantovani, A.L.; Alves, J.M.; Oliveira, P.F.; Tavares, D.C.; et al. Chemical composition and in vitro schistosomicidal activity of the essential oil of Plectranthus neochilus grown in Southeast Brazil. Chem. Biodiver. 2011, 8, 2149–2157. [Google Scholar] [CrossRef]
- Baldin, E.L.; Crotti, A.E.; Wakabayashi, K.A.; Silva, J.P.; Aguiar, G.P.; Souza, E.S.; Veneziani, R.C.; Groppo, M. Plant-derived essential oils affecting settlement and oviposition of Bemisia tabaci (Genn.) biotype B on tomato. J. Pest. Sci. 2013, 86, 301–308. [Google Scholar] [CrossRef]
- Viana, A.J.S. Estudo Químico e de Atividade Aiológica de Plectranthus Neochilus Schltr. (Lamiaceae). Master’s Thesis, Federal University of Vales do Jequitinhonha e Mucuri, Teófilo Otoni, Brasil, 2011. (In Spanish). [Google Scholar]
- Matias, D.; Nicolai, M.; Fernandes, A.S.; Saraiva, N.; Almeida, J.; Saraiva, L.; Faustino, C.; Díaz-Lanza, A.M.; Reis, C.P.; Rijo, P. Comparison Study of Different Extracts of Plectranthus madagascariensis, P. neochilus and the Rare P. porcatus (Lamiaceae): Chemical Characterization, Antioxidant, Antimicrobial and Cytotoxic Activities. Biomolecules 2019, 9, 179. [Google Scholar] [CrossRef] [PubMed]
- Invasive Species Compendium, Parthenocissus quinquefolia (Virginia creeper). Available online: https://www.cabi.org/isc/datasheet/44676 (accessed on 21 November 2019).
- Gledhill, D. The Names of Plants, 3rd ed.; Cambridge University Press: Cambridge, UK, 2010; pp. 292, 324, ISBN 9780521866453 (hardback), ISBN 9780521685535 (paperback). [Google Scholar] [CrossRef]
- Shaheen, S.; Manzoor, A. Phytochemical screening and antioxidant potential of Parthenocissus quinquefolia (L.) planch extracts of bark and stem. Pak. J. Pharm. Sci. 2018, 31, 1813–1816. [Google Scholar]
- Yang, J.; Wang, A.; Ji, T.; Su, Y. Chemical constituents from Parthenocissus quinquefolia. Zhongguo Zhong yao za zhi Zhongguo zhongyao zazhi China J. Chin. Mater. Medica 2010, 35, 1573–1576. [Google Scholar]
- Khan, Z.U.D.; Faisal, S.; Perveen, A.; Sardar, A.A.; Siddiqui, S.Z. Phytochemical properties and antioxidant activities of leaves and fruits extracts of Parthenocissus quinquefolia (L.) Planch. Bang J. Bot. 2018, 47, 33–38. [Google Scholar]
- Cardon, D. Natural Dyes, Sources Tradition. Technology and Science; Archetype: London, UK, 2007; p. 778. ISBN 190498200X, 9781904982005. [Google Scholar]
- Francis, F.J. Colorants; Egan Press: St. Paul, MN, USA, 1999; ISBN 1-891127-00-4. [Google Scholar]
- Stafford, H.A. Anthocyanins and betalains: Evolution of the mutually exclusive pathways. Plant. Sci. 1994, 101, 91–98. [Google Scholar] [CrossRef]
- Gai, C.Y.; Liu, H.M.; Li, J.; Li, J. Extraction and Content Determination of Total Flavonoid in Parthenocissus Quinquefolia. Spec. Wild Econ. Anim. Plant. Res. 2010, 2, 20. [Google Scholar]
- Shi, J.; Han, X.; Zhang, Y.; Sun, T.; Diao, H.; Cao, X. Extraction techniques and identification of flavonoids in parthenocissus seeds. China Med. Her. 2010, 18, 33. [Google Scholar]
- Naik, M.K.; Prasad, Y.; Bhat, K.V.; Rani, D. Morphological, physiological, pathogenic and molecular variability among isolates of Alternaria solani from tomato. Indian Phytopathol. 2010, 63, 168–173. [Google Scholar]
- Johnston, A.; Booth, C. Plant Pathologist’s Pocket Book; Oxford and IBH Pub. Co.: Calcutta, India, 1983; p. 136. [Google Scholar]
- Agrios, G.N. Plant Pathology, 5th ed.; Elsevier Academic Press: Burlington, MA, USA, 2005; pp. 79–103. [Google Scholar]
- Hussein, G.S. The use of PCR to detect Alternaria fungi which isolated from tomato fruit. Biochem. Cell. Arch. 2019, 19, 4203–4206. [Google Scholar]
- Chohan, S.; Perveen, R.; Abid, M.; Naz, M.S.; Akram, N. Morpho-physiological Studies Management and Screening of Tomato Germplasm against Alternaria solani the Causal Agent of Tomato Early Blight. Int. J. Agric. Biol. 2015, 17, 111–118. [Google Scholar]
- Barratt, R.W.; Horsfall, J.G. An improved grading system for measuring plant disease. Phytopathology 1945, 35, 655. [Google Scholar]
- Pandey, K.K.; Pandey, P.K.; Kalloo, G.; Banerjee, M.K. Resistance to early blight of tomato with respect to various parameters of disease epidemics. J. Gen. Plant. Pathol. 2003, 69, 364–371. [Google Scholar] [CrossRef]
- Edel, V.; Christian, S.; Gautheron, N.; Recorbet, G.; Alabouvette, C. Genetic diversity of Fusarium oxysporum populations isolated from different soils in France. FEMS Microbiol. Ecol. 2001, 36, 61–71. [Google Scholar] [CrossRef]
- Mohamed, A.A.; Gomaa, F.H. Molecular Characterization and Biological Control of Some Rice Seed-borne Fungal Pathogens. J. Phytopathol. Pest. Manag. 2019, 6, 40–53. [Google Scholar]
- Kumar, S.; Stecher, G.; Tamura, K. MEGA7: Molecular Evolutionary Genetics Analysis version 7.0 for bigger datasets. Mol. Biol. Evol. 2016, 33, 1870–1874. [Google Scholar] [CrossRef]
- Mount, D.W. Maximum parsimony method for phylogenetic prediction. Cold Spring Harb. Protoc. 2008, 2008. [Google Scholar] [CrossRef]
- Molloy, D.P. Biological control of Zebra mussels. In Proceedings of the 3rd California Conference on Biological Control, University of California, Davis, CA, USA, 15–16 August 2002; pp. 86–94. [Google Scholar]
- Salem, M.Z.M.; Mansour, M.M.; Elansary, H.O. Evaluation of the effect of inner and outer bark extracts of Sugar Maple (Acer saccharum var. saccharum) in combination with citric acid against the growth of three common molds. J. Wood Chem. Technol. 2019, 39, 136–147. [Google Scholar] [CrossRef]
- Salem, M.Z.M.; Ali, H.M.; El-Shanhorey, N.A.; Abdel-Megeed, A. Evaluation of extracts and essential oil from Callistemon viminalis leaves: Antibacterial and antioxidant activities, total phenolic and flavonoid contents. Asian Pac. J. Trop. Med. 2013, 6, 785–791. [Google Scholar] [CrossRef]
- Nene, Y.L.; Thapaya, P.N. Evaluation of fungicides. In Fungicide in Plant Disease Control; Oxford and IBH Publishing Company: New Delhi, India, 1993; p. 531. [Google Scholar]
- EL-Hefny, M.; Salem, M.Z.M.; Behiry, S.I.; Ali, H.M. The Potential Antibacterial and Antifungal Activities of Wood Treated with Withania somnifera Fruit Extract, and the Phenolic, Caffeine, and Flavonoid Composition of the Extract According to HPLC. Processes 2020, 8, 113. [Google Scholar] [CrossRef]
- Al-Huqail, A.A.; Behiry, S.I.; Salem, M.Z.M.; Ali, H.M.; Siddiqui, M.H.; Salem, A.Z.M. Antifungal, antibacterial, and antioxidant activities of Acacia saligna (Labill.) HL Wendl. flower extract: HPLC analysis of phenolic and flavonoid compounds. Molecules 2019, 24, 700. [Google Scholar] [CrossRef]
- Derbalah, A.S.; El-Mahrouk, M.S.; El-Sayed, A.B. Efficacy and safety of some plant extracts against tomato early blight disease caused by Alternaria solani. Plant. Pathol. J. 2011, 10, 115–121. [Google Scholar] [CrossRef]
- NAShwA, S.M.; Abo-ElyouSr, K.A. Evaluation of various plant extracts against the early blight disease of tomato plants under greenhouse and field conditions. Plant. Prot. Sci. 2013, 4, 74–79. [Google Scholar] [CrossRef]
- Qasem, J.R.; Abu-Blan, H.A. Fungicidal activity of some common weed extracts against different plant pathogenic fungi. J. Phytopathol. 1996, 144, 157–161. [Google Scholar] [CrossRef]
- Sundar, A.R.; Das, N.D.; Krishnaveni, D. In-vitro Antagonism of Trichoderma spp. against two Fungal Pathogens of Castor. Ind. J. Plant. Prot. 1995, 23, 152–155. [Google Scholar]
- El-Katatny, M.H.; Emam, A.S. Control of postharvest tomato rot by spore suspension and antifungal metabolites of Trichoderma harzianum. J. Microbiol. Biotech. Food Sci. 2012, 1, 1505–1528. [Google Scholar]
- Wheeler, B.E.J. An Introduction to Plant Diseases; J. Wiley and Sons Limited: London, UK, 1969; p. 301. [Google Scholar]
- SAS. User Guide: Statistics (Release 8.02); SAS Institute: Cary, NC, USA, 2001. [Google Scholar]
- Ashour, A.M.A. A protocol suggested for managing tomato early blight. Egypt J. Phytopathol. 2009, 37, 9–20. [Google Scholar]
- Simmons, E. Alternaria: An Identification Manual; CBS Fungal Biodiversity Centre: Utrecht, The Netherlands, 2007. [Google Scholar]
- Ellis, M.B. Dematiaceous Hyphomycetes; Commonwelth Mycological Institute: Kew, UK, 1971; p. 608. [Google Scholar]
- Ramjegathesh, R.; Ebenezar, E.G. Morphological and physiological characters of Alternaria Alternata causing leaf blight diseases of onion. Int. J. Plant. Pathol. 2012, 3, 34–44. [Google Scholar] [CrossRef][Green Version]
- Dang, H.X.; Pryor, B.; Peever, T.; Lawrence, C.B. The Alternaria genomes database: A comprehensive resource for a fungal genus comprised of saprophytes, plant pathogens, and allergenic species. BMC Genom. 2015, 16, 239. [Google Scholar] [CrossRef]
- Pryor, B.M.; Michailides, T.J. Morphological, Pathogenic, and Molecular Characterization of Alternaria Isolates Associated with Alternaria Late Blight of Pistachio. Phytopathology 2002, 92, 406–416. [Google Scholar] [CrossRef]
- Kusaba, M.; Tsuge, T. Phologeny of Alternaria fungi known to produce host-specific toxins on the basis of variation in internal transcribed spacers of ribosomal DNA. Curr. Genet. 1995, 28, 491–498. [Google Scholar] [CrossRef] [PubMed]
- Xie, G.; Tan, S.; Yu, L. Morphological and molecular identification of pathogenic fungal of post-harvest tomato fruit during storage. Afr. J. Microbiol. Res. 2012, 6, 4805–4809. [Google Scholar]
- Peralta, I.E.; Knapp, S.; Spooner, D.M. New species of wild tomatoes (Solanum section Lycopersicon: Solanaceae) from Northern Peru. Syst. Bot. 2005, 30, 424–434. [Google Scholar] [CrossRef]
- Chaerani, R.; Voorrips, R.E.; Roeland, E. Tomato early blight (Alternaria solani): The pathogen, genetics and breeding for resistance. J. Gen. Plant. Pathol. 2006, 13, 335–347. [Google Scholar] [CrossRef]
- Behiry, S.I.; EL-Hefny, M.; Salem, M.Z.M. Toxicity effects of Eriocephalus africanus L. leaf essential oil against some molecularly identified phytopathogenic bacterial strains. Nat. Prod. Res. 2020, 34, 3394–3398. [Google Scholar] [CrossRef]
- Ashmawy, N.A.; Behiry, S.I.; Al-Huqail, A.A.; Ali, H.M.; Salem, M.Z.M. Bioactivity of Selected Phenolic Acids and Hexane Extracts from Bougainvilla spectabilis and Citharexylum spinosum on the Growth of Pectobacterium carotovorum and Dickeya solani Bacteria: An Opportunity to Save the Environment. Processes 2020, 8, 482. [Google Scholar] [CrossRef]
- Adhikari, P.; Oh, Y.; Panthee, D.R. Current status of early blight resistance in tomato: An update. Int. J. Mol. Sci. 2017, 18, 2019. [Google Scholar] [CrossRef]
- Aldiba, A.; Escov, I. Biological Control of Early Blight on Potato Caused by Alternaria Solani by Some Bioagents. In Proceedings of the 1st International Symposium Innovations in Life Sciences (ISILS 2019), Belgorod, Russia, 10–11 October 2019; Atlantis Press: Paris, France, 2019; pp. 103–107. [Google Scholar] [CrossRef]
- Evidente, A.; Andolfi, A. Fungal phytotoxins for control of cirsium arvense and Sonchus arvensis. Pest. Technol. 2011, 5, 1–17. [Google Scholar]
- Mercado-Blanco, J.; Bakker, P.A. Interactions between plants and beneficial Pseudomonas spp.: Exploiting bacterial traits for crop protection. Antonie van Leeuwenhoek 2007, 92, 367–389. [Google Scholar] [CrossRef]
- Drehe, I.; Simonetti, E.; Ruiz, J.A. Contribution of the siderophores pyoverdine and enantio-pyochelin to fitness in soil of Pseudomonas protegens Pf-5. Curr. Microbiol. 2018, 75, 1560–1565. [Google Scholar] [CrossRef]
- Latha, P.; Anand, T.; Prakasam, V.; Jonathan, E.I.; Paramathma, M.; Samiyappan, R. Combining Pseudomonas, Bacillus an Trichoderma strains with organic amendments and micronutrient to enhance suppression of collar and root rot disease in physic nut. Appl. Soil Ecol. 2011, 49, 215–223. [Google Scholar] [CrossRef]
- Zape, A.S.; Gade, R.M.; Singh, R.A.V.I.N.D.R.A.; Deshmukh, V.A. Efficacy of different antagonist against the Sclerotium rolfsii, Rhizoctonia solani and Fusarium solani. Bioscan 2014, 9, 1431–1434. [Google Scholar]
- Vallabhaneni, S.D. Biocontrol of Rhizoctonia solani in tobacco (Nicotiana tabacum) seed beds using Pseudomonas fluorescens. Agric. Res. 2016, 5, 137–144. [Google Scholar] [CrossRef]
- Casida, L.E.; Lukezic, F.L. Control of leaf spot diseases of alfalfa and tomato with applications of the bacterial predator Pseudomonas strain 679-2. Plant Dis. 1992, 76, 1217. [Google Scholar] [CrossRef]
- Mohamed, H.A.; Haggag, W.M. Biocontrol potential of salinity tolerant mutants of Trichoderma harzianum against Fusarium oxysporum. Braz. J. Microbiol. 2006, 37, 181–191. [Google Scholar] [CrossRef][Green Version]
- Montealegre, J.; Valderrama, L.; Sanchez, S.; Herrera, R.; Besoainand, X.; Perez, L.M. Biological control of Rhizoctonia solani intomatoes with Trichoderma harzianum mutants. Electron. J. Biotechnol. 2010, 13, 1–11. [Google Scholar] [CrossRef][Green Version]
- Mandal, D.; Pal, R.; Mohanty, A.K. Management of bacterial leaf blight of rice in an integrated way. J. Mycopathol. Res. 2017, 54, 539–541. [Google Scholar]
- Singh, P.C.; Singh, D. In vitro evaluation of fungicides against Alternaria alternata. Ann. Plant Prot. Sci. 2006, 14, 500–502. [Google Scholar]
- Mesta, R.K.; Benagi, V.I.; Shankergroud, I.; Megeri, S.N. Effect of dates of sowing and correlation of weather parameters on the incidence of Alternaria blight of sunflower. Karnataka J. Agric. Sci. 2009, 22, 441–443. [Google Scholar]
- Lattanzio, V.; Lattanzio, V.M.; Cardinali, A. Role of phenolics in the resistance mechanisms of plants against fungal pathogens and insects. Phytochem. Adv. Res. 2006, 661, 23–67. [Google Scholar]
- Heyman, J.; Canher, B.; Bisht, A.; Christiaens, F.; De Veylder, L. Emerging role of the plant ERF transcription factors in coordinating wound defense responses and repair. J. Cell Sci. 2018, 131, jcs.208215. [Google Scholar] [CrossRef] [PubMed]
- Brotman, Y.; Landau, U.; Cuadros-Inostroza, Á.; Takayuki, T.; Fernie, A.R.; Chet, I.; Viterbo, A.; Willmitzer, L. Trichoderma-plant root colonization: Escaping early plant defense responses and activation of the antioxidant machinery for saline stress tolerance. PLoS Pathog. 2013, 9, e1003221. [Google Scholar] [CrossRef]
- Heil, M.; Bostock, R.M. Induced systemic resistance (ISR) against pathogens in the context of induced plant defences. Ann. Bot. 2002, 89, 503–512. [Google Scholar] [CrossRef] [PubMed]
- Kokoskova, B.; Pavela, R.; Pouvova, D. Effectiveness of plant essential oils against Erwinia amylovora, Pseudomonas syringae pv. syringae and associated saprophytic bacteria on/in host plants. J. Plant. Pathol. 2011, 93, 133–139. [Google Scholar]
- Shen, L.; Wang, F.; Yang, J.; Qian, Y.; Dong, X.; Zhan, H. Control of tobacco mosaic virus by Pseudomonas fluorescens CZ powder in greenhouses and the field. Crop. Prot. 2014, 56, 87–90. [Google Scholar] [CrossRef]
- Nandakumar, R.; Babu, S.; Viswanathan, R.; Raguchander, T.; Samiyappan, R. Induction of systemic resistance in rice against sheath blight disease by Pseudomonas fluorescens. Soil Biol. Biochem. 2001, 33, 603–612. [Google Scholar] [CrossRef]
- Deice Raasch-Fernandes, L.; Bonaldo, S.M.; de Jesus Rodrigues, D.; Magela Vieira-Junior, G.; Regina Freitas Schwan-Estrada, K.; Rocco da Silva, C.; Gabriela Araújo Verçosa, A.; Lopes de Oliveira, D.; Wender Debiasi, B. Induction of phytoalexins and proteins related to pathogenesis in plants treated with extracts of cutaneous secretions of southern Amazonian Bufonidae amphibians. PLoS ONE 2019, 14, e0211020. [Google Scholar] [CrossRef]
- Meena, B.; Radhajeyalakshmi, R.; Marimuthu, T.; Vidhyasekaran, P.; Doraiswamy, S.; Velazhahan, R. Induction of pathogenesis-related proteins, phenolics and phenylalanine ammonia-lyase in groundnut by Pseudomonas fluorescens. J. Plant. Dis. Prot. 2000, 107, 514–527. [Google Scholar]
- Sivakumar, G.; Sharma, R.C. Induced biochemical changes due to seed bacterization by Pseudomonas fluorescens in maize plants. Indian Phytopathol. 2003, 56, 34–137. [Google Scholar]
- Akram, A.; Ongena, M.; Duby, F.; Dommes, J.; Thonart, P. Systemic resistance and lipoxygenase-related defence response induced in tomato by Pseudomonas putida strain BTP1. BMC Plant Biol. 2008, 8, 1–12. [Google Scholar] [CrossRef]
- Trouvelot, S.; Varnier, A.L.; Allegre, M.; Mercier, L.; Baillieul, F.; Arnould, C.; Gianinazzi-Pearson, V.; Klarzynski, O.; Joubert, J.M.; Pugin, A.; et al. A β-1, 3 glucan sulfate induces resistance in grapevine against Plasmopara viticola through priming of defense responses, including HR-like cell death. Mol. Plant. Microbe Interact. 2008, 21, 232–243. [Google Scholar] [CrossRef]
- Cohen, Y.; Rubin, A.E.; Kilfin, G. Mechanisms of induced resistance in lettuce against Bremia lactucae by DL-β-amino-butyric acid (BABA). Eur. J. Plant. Pathol. 2010, 126, 553–573. [Google Scholar] [CrossRef]
- Cushnie, T.T.; Lamb, A.J. Antimicrobial activity of flavonoids. Inter. J. Antimicrob. Agent. 2005, 26, 343–356. [Google Scholar] [CrossRef]
- Peralta, M.A.; da Silva, M.A.; Ortega, M.G.; Cabrera, J.L.; Paraje, M.G. Antifungal activity of a prenylated flavonoid from Dalea elegans against Candida albicans biofilms. Phytomedicine 2015, 22, 975–980. [Google Scholar] [CrossRef]
- Al Aboody, M.S.; Mickymaray, S. Anti-fungal efficacy and mechanisms of flavonoids. Antibiotics 2020, 9, 45. [Google Scholar] [CrossRef] [PubMed]
- Nair, M.S.; Saxena, A.; Kaur, C. Characterization and antifungal activity of pomegranate peel extract and its use in polysaccharide-based edible coatings to extend the shelf-life of capsicum (Capsicum annuum L.). Food Bioproc. Technol. 2018, 11, 1317–1327. [Google Scholar] [CrossRef]
- Havsteen, B.H. The biochemistry and medical significance of the flavonoids. Pharmacol. Therap. 2002, 96, 67–202. [Google Scholar] [CrossRef]
- Edris, A.E. Pharmaceutical and therapeutic potentials of essential oils and their individual volatile constituents, a review. Phytother. Res. 2007, 21, 308–323. [Google Scholar] [CrossRef]
- Rattanata, N.; Daduang, S.; Phaetchanla, S.; Bunyatratchata, W.; Promraksa, B.; Tavichakorntrakool, R.; Uthaiwat, P.; Boonsiri, P.; Daduang, J. Antioxidant and antibacterial properties of selected Thai weed extracts. Asian Pac. J. Trop. Biomed. 2014, 4, 890–895. [Google Scholar] [CrossRef]

| Number | Symptoms |
|---|---|
| 0 | No symptom spot on the leaf |
| 1 | 1–20% leaf area infected and covered by spot |
| 2 | 21–40% leaf area infected and covered by spot |
| 3 | 41–60% leaf area infected and covered by spot |
| 4 | 61–80% leaf area infected and covered by spot |
| 5 | 80% leaf area infected and covered by spot |
| Isolates Codes | Cultivars | Plant Parts | Accession Number | Percent Disease Index (PDI) * |
|---|---|---|---|---|
| A.s.1 | Dosera | Tomato fruit | MT279570 | 45% |
| A.s.2 | 023 | Tomato fruit | MT279571 | 30% |
| A.s.3 | Marina Hajin F2 | Tomato leaves | MT279572 | 25% |
| A.s.4 | Ajyad 7 | Tomato leaves | MT279573 | 20% |
| Treatment | Concentration | Inhibition Percentage of Fungal Growth (IPFG) % | |||
|---|---|---|---|---|---|
| A.s.1 | A.s.2 | A.s.3 | A.s.4 | ||
| T. viride | 106 spore/mL | 72.99 ± 0.42 b * | 71.43 ± 0.75 c | 65.26 ± 0.47 c | 63.98 ± 1.42 c |
| P. fluorescens | 108 CFU/mL | 67.93 ± 0.42 c | 64.93 ± 0.74 d | 49.76 ± 0.93 d | 53.76 ± 0.53 d |
| P. neochilus extract | 625 mg/L | 48.11 ± 0.73 e | 28.57 ± 0.75 h | 23.94 ± 1.62 g | 10.21 ± 0.53 g |
| 1250 mg/L | 51.89 ± 0.73 de | 41.56 ± 0.75 fg | 28.17 ± 0.81 ef | 31.18 ± 1.42 f | |
| 2500 mg/L | 54.01 ± 1.69 d | 50.21 ± 1.56 e | 31.45 ± 0.46 e | 37.09 ± 0.93 e | |
| P. quinquefolia extract | 625 mg/L | 48.52 ± 0.84 e | 39.39 ± 1.56 g | 26.76 ± 0.81 fg | 7.52± 1.42 g |
| 1250 mg/L | 50.63 ± 0.73 de | 45.45 ± 1.98 ef | 28.17 ± 0.81 ef | 30.64 ± 0.93 f | |
| 2500 mg/L | 54.01 ± 1.11 d | 48.05 ± 0.74 e | 30.98 ± 0.81 e | 35.48 ± 0.93 ef | |
| Chlorothalonil fungicide (Chemical positive control) | 625 mg/L | 73.70 ± 0.37 b | 73.71 ± 0.98 bc | 75.93 ± 0.37 b | 74.44 ± 1.28 b |
| 1250 mg/L | 76.67 ± 0.00 ab | 77.78 ± 0.64 ab | 80.74 ± 0.37 a | 78.89 ± 0.64 ab | |
| 2500 mg/L | 77.78 ± 0.64 a | 82.59 ± 0.97 a | 84.44 ± 0.64 a | 81.85 ± 0.74 a | |
| Control | 0 | 0.0 f | 0.0 i | 0.0 h | 0.0 h |
| Minimum Significant Difference * | 3.98 | 5.49 | 3.97 | 5.07 | |
| p-value | <0.0001 | 0.0005 | <0.0001 | <0.0001 | |
| Flavonoid Compound | Flavonoids (mg/100 g of Plant Extract) | |
|---|---|---|
| P. neochilus (Leaves) | P. quinquefolia (Fruits) | |
| Rutin | 2429.60 | 1891.60 |
| Myricetin | 75.92 | 241.06 |
| Quercetin | ND * | ND |
| Naringenin | ND | ND |
| Kaempferol | ND | ND |
| Apigenin | ND | ND |
| Treatments | Concentration | PDI * % | Reduction in PDI % |
|---|---|---|---|
| T. viride | 106 spore/mL | 20 | 80 |
| P. fluorescens | 108 CFU/mL | 25 | 75 |
| P. neochilus extract | 2500 mg/L | 30 | 70 |
| P. quinquefolia extract | 2500 mg/L | 35 | 65 |
| Chlorothalonil fungicide | 2500 mg/L | 20 | 80 |
| Control Alternaria | 3 × 106 spore/mL | 100 | -- |
Publisher’s Note: MDPI stays neutral with regard to jurisdictional claims in published maps and institutional affiliations. |
© 2021 by the authors. Licensee MDPI, Basel, Switzerland. This article is an open access article distributed under the terms and conditions of the Creative Commons Attribution (CC BY) license (https://creativecommons.org/licenses/by/4.0/).
Share and Cite
Mohamed, A.A.; Salah, M.M.; El-Dein, M.M.Z.; EL-Hefny, M.; Ali, H.M.; Farraj, D.A.A.; Hatamleh, A.A.; Salem, M.Z.M.; Ashmawy, N.A. Ecofriendly Bioagents, Parthenocissus quinquefolia, and Plectranthus neochilus Extracts to Control the Early Blight Pathogen (Alternaria solani) in Tomato. Agronomy 2021, 11, 911. https://doi.org/10.3390/agronomy11050911
Mohamed AA, Salah MM, El-Dein MMZ, EL-Hefny M, Ali HM, Farraj DAA, Hatamleh AA, Salem MZM, Ashmawy NA. Ecofriendly Bioagents, Parthenocissus quinquefolia, and Plectranthus neochilus Extracts to Control the Early Blight Pathogen (Alternaria solani) in Tomato. Agronomy. 2021; 11(5):911. https://doi.org/10.3390/agronomy11050911
Chicago/Turabian StyleMohamed, Abeer A., Mohsen M. Salah, Manal M. Zen El-Dein, Mervat EL-Hefny, Hayssam M. Ali, Dunia A. Al Farraj, Ashraf A. Hatamleh, Mohamed Z. M. Salem, and Nader A. Ashmawy. 2021. "Ecofriendly Bioagents, Parthenocissus quinquefolia, and Plectranthus neochilus Extracts to Control the Early Blight Pathogen (Alternaria solani) in Tomato" Agronomy 11, no. 5: 911. https://doi.org/10.3390/agronomy11050911
APA StyleMohamed, A. A., Salah, M. M., El-Dein, M. M. Z., EL-Hefny, M., Ali, H. M., Farraj, D. A. A., Hatamleh, A. A., Salem, M. Z. M., & Ashmawy, N. A. (2021). Ecofriendly Bioagents, Parthenocissus quinquefolia, and Plectranthus neochilus Extracts to Control the Early Blight Pathogen (Alternaria solani) in Tomato. Agronomy, 11(5), 911. https://doi.org/10.3390/agronomy11050911








